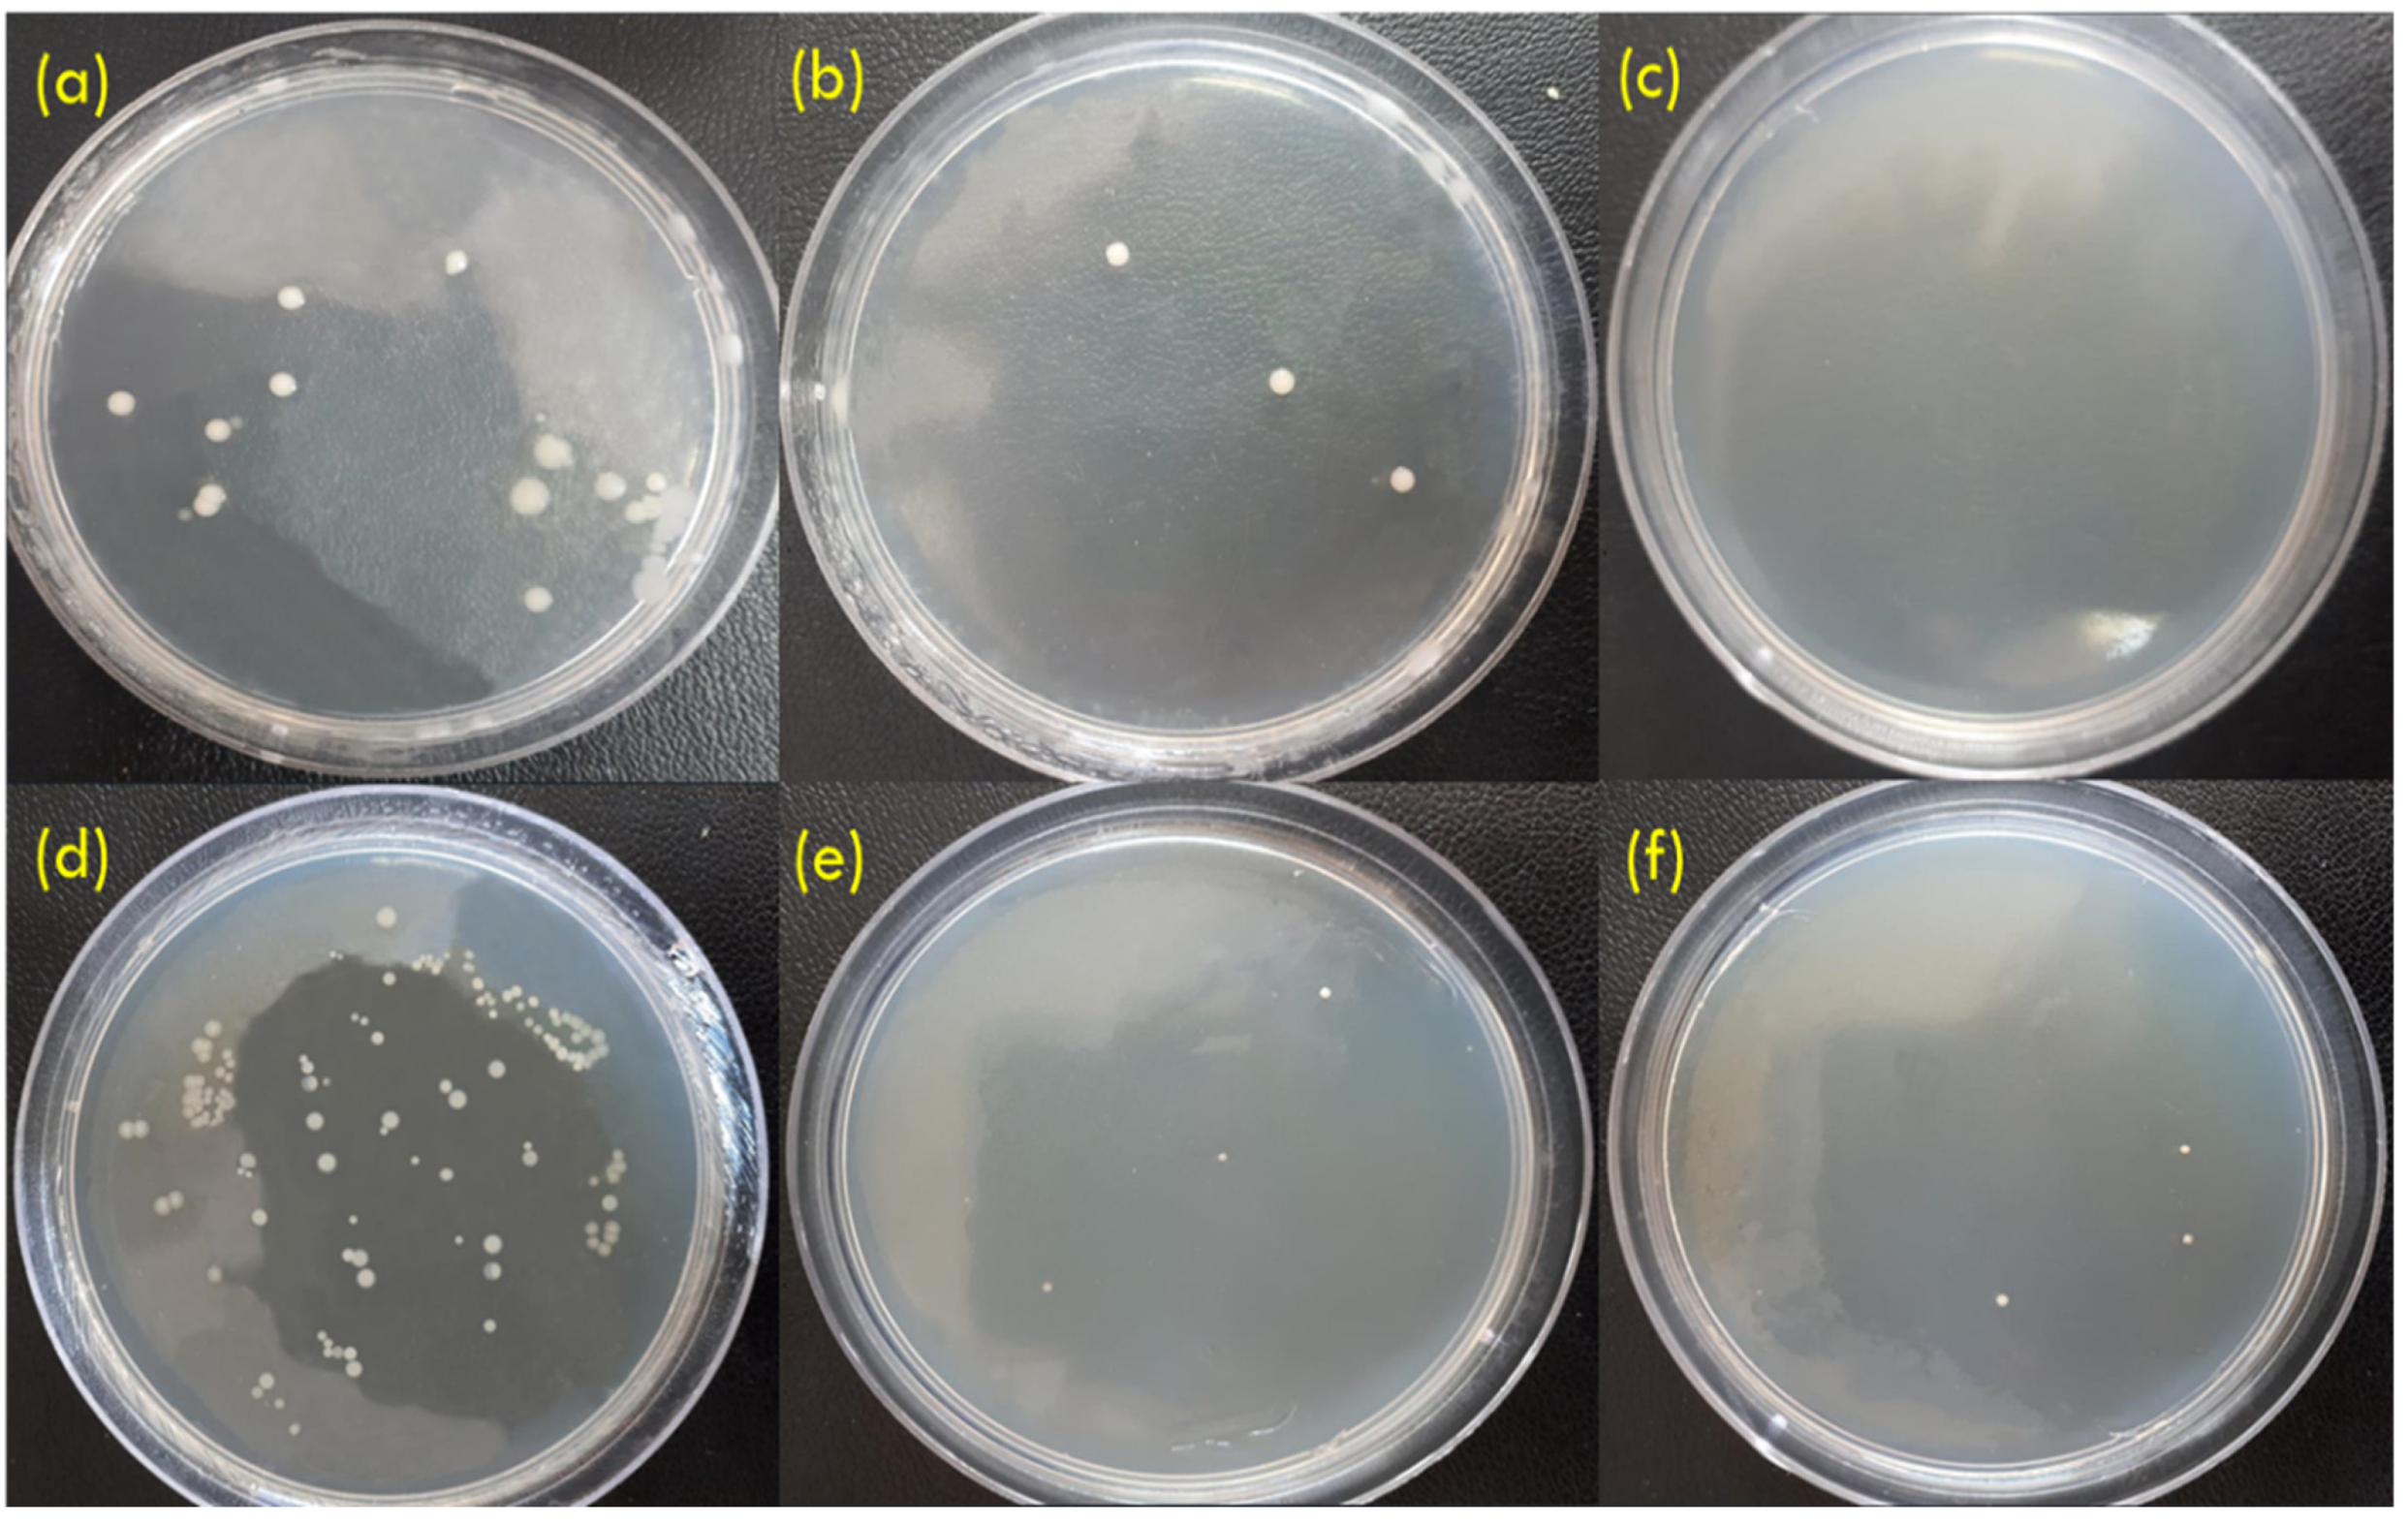
Coatings 14 01522 g011

Surface Modification of Anodized Titanium Surfaces with Chitosan/ε-Polylysine Coating, Aiming for Improved Bioactivity, Biocompatibility, and Anti-Bacterial Properties for Orthopedic Applications
Abstract
1. Introduction
2. Materials and Methods
2.1. Materials
2.2. Sample Preparation
2.3. Materials Characterizations
2.4. Biological Characterizations
3. Result and Discussion
3.1. FTIR-ATR Analysis
3.2. Stereomicroscope Results
3.3. FE-SEM Microscopy
3.4. Contact Angle Measurements
3.5. Surface Roughness Evaluations
3.6. MTT Test Results
3.7. Anti-Bacterial Evaluations
3.8. ICP Test/pH Measurements
3.9. Bioactivity Test
3.10. Degradation Tests
4. Conclusions
Author Contributions
Funding
Institutional Review Board Statement
Informed Consent Statement
Data Availability Statement
Conflicts of Interest
References
- Xu, Y.; Zhang, F.; Zhai, W.; Cheng, S.; Li, J.; Wang, Y. Unraveling of Advances in 3D-Printed Polymer-Based Bone Scaffolds. Polymers 2022, 14, 566. [Google Scholar] [CrossRef] [PubMed]
- Zhao, Y.; Liu, Y.; Kang, S.; Sun, D.; Liu, Y.; Wang, X.; Lu, L. Peripheral nerve injury repair by electrical stimulation combined with graphene-based scaffolds. Front. Bioeng. Biotechnol. 2024, 12, 1345163. [Google Scholar] [CrossRef] [PubMed]
- Zhang, L.; Shi, H.; Tan, X.; Jiang, Z.; Wang, P.; Qin, J. Ten-gram-scale mechanochemical synthesis of ternary lanthanum coordination polymers for antibacterial and antitumor activities. Front. Chem. 2022, 10, 898324. [Google Scholar] [CrossRef] [PubMed]
- Ras, J.; Leach, L. Relationship Between Physical Activity, Coronary Artery Disease Risk Factors and Musculoskeletal Injuries in the City of Cape Town Fire and Rescue Service. Inquiry 2022, 59, 00469580221084485. [Google Scholar] [CrossRef] [PubMed]
- Coyac, B.R.; Wu, M.; Bahat, D.J.; Wolf, B.J.; Helms, J.A. Biology of sinus floor augmentation with an autograft versus a bone graft substitute in a preclinical in vivo experimental model. Clin. Oral Implant. Res. 2021, 32, 916–927. [Google Scholar] [CrossRef] [PubMed]
- Chen, Z.; Zhang, Z.; Wang, Z.; Wu, J.; Wang, Y.; Si, H.; Xie, X.; Shang, L.; Fan, D.; Chen, F. Fabricating a novel HLC-hBMP2 fusion protein for the treatment of bone defects. J. Control. Release 2021, 329, 270–285. [Google Scholar] [CrossRef]
- Baron, M.; Drohat, P.; Crawford, B.; Hornicek, F.J.; Best, T.M.; Kouroupis, D. Mesenchymal Stem/Stromal Cells: Immunomodulatory and Bone Regeneration Potential after Tumor Excision in Osteosarcoma Patients. Bioengineering 2023, 10, 1187. [Google Scholar] [CrossRef]
- Guo, Y.; Xie, B.; Jiang, M.; Yuan, L.; Jiang, X.; Li, S.; Cai, R.; Chen, J.; Jiang, X.; He, Y.; et al. Facile and eco-friendly fabrication of biocompatible hydrogel containing CuS@Ser NPs with mechanical flexibility and photothermal antibacterial activity to promote infected wound healing. J. Nanobiotechnol. 2023, 21, 266. [Google Scholar] [CrossRef]
- Ong, V.; Soleimani, A.; Amirghasemi, F.; Khazaee Nejad, S.; Abdelmonem, M.; Razaviyayn, M.; Hosseinzadeh, P.; Comai, L.; Mousavi, M.P. Impedimetric Sensing: An Emerging Tool for Combating the COVID-19 Pandemic. Biosensors 2023, 13, 204. [Google Scholar] [CrossRef]
- Watson, E.; Mikos, A.G. Advances in In Vitro and In Vivo Bioreactor-Based Bone Generation for Craniofacial Tissue Engineering. BME Front. 2023, 4, 0004. [Google Scholar] [CrossRef]
- Cakir, F.; Özkal, F.M.; Sensoz, E. Performance Assessment of Biocompatible Metals Used in the Treatment of Femoral Neck Fractures. ACS Appl. Bio Mater. 2022, 5, 3013–3022. [Google Scholar] [CrossRef] [PubMed]
- Abbasi, M.S.; Saber, F.Y.; Bahrami, A.; Torkian, S.; Hosseini-Abari, A. Towards an anticancer bioactive glass-Fe3O4/Pectin/Pectic oligosaccharide coatings for biomedical applications. Surf. Interfaces 2024, 45, 103874. [Google Scholar] [CrossRef]
- Heidari Laybidi, F.; Bahrami, A.; Abbasi, M.S.; Rajabinezhad, M.; Heidari Beni, B.; Karampoor, M.R.; Mousavi Anijdan, S.H. Electrophoretic Deposition of ZnO-Containing Bioactive Glass Coatings on AISI 316L Stainless Steel for Biomedical Applications. Coatings 2023, 13, 1946. [Google Scholar] [CrossRef]
- Torkian, N.; Bahrami, A.; Hosseini-Abari, A.; Momeni, M.M.; Abdolkarimi-Mahabadi, M.; Bayat, A.; Hajipour, P.; Rourani, H.A.; Abbasi, M.S.; Torkian, S.; et al. Synthesis and characterization of Ag-ion-exchanged zeolite/TiO2 nanocomposites for antibacterial applications and photocatalytic degradation of antibiotics. Environ. Res. 2022, 207, 112157. [Google Scholar] [CrossRef]
- Gulati, K.; Ding, C.; Guo, T.; Guo, H.; Yu, H.; Liu, Y. Craniofacial therapy: Advanced local therapies from nano-engineered titanium implants to treat craniofacial conditions. Int. J. Oral Sci. 2023, 15, 15. [Google Scholar] [CrossRef]
- Kiarashi, M.; Mahamed, P.; Ghotbi, N.; Tadayonfard, A.; Nasiri, K.; Kazemi, P.; Badkoobeh, A.; Yasamineh, S.; Joudaki, A. Spotlight on therapeutic efficiency of green synthesis metals and their oxide nanoparticles in periodontitis. J. Nanobiotechnol. 2024, 22, 21. [Google Scholar] [CrossRef]
- Wang, M.; Yao, Q.; Qu, S.; Chen, Y.; Li, H.; Chen, L. Preparation and Thermoelectric Properties of Semiconducting Single-Walled Carbon Nanotubes/Regioregular Poly(3-dodecylthiophene) Composite Films. Polymers 2020, 12, 2720. [Google Scholar] [CrossRef]
- Bispo, M.; Santos, S.B.; Melo, L.D.; Azeredo, J.; van Dijl, J.M. Targeted Antimicrobial Photodynamic Therapy of Biofilm-Embedded and Intracellular Staphylococci with a Phage Endolysin’s Cell Binding Domain. Microbiol. Spectr. 2022, 10, e0146621. [Google Scholar] [CrossRef]
- Pihl, M.; Galli, S.; Jimbo, R.; Andersson, M. Osseointegration and antibacterial effect of an antimicrobial peptide releasing mesoporous titania implant. J. Biomed. Mater. Res. Part B Appl. Biomater. 2021, 109, 1787–1795. [Google Scholar] [CrossRef] [PubMed]
- López-Valverde, N.; Aragoneses, J.; López-Valverde, A.; Rodríguez, C.; Macedo de Sousa, B.; Aragoneses, J.M. Role of chitosan in titanium coatings. trends and new generations of coatings. Front. Bioeng. Biotechnol. 2022, 10, 907589. [Google Scholar] [CrossRef]
- Riool, M.; de Breij, A.; Drijfhout, J.W.; Nibbering, P.H.; Zaat, S.A. Antimicrobial peptides in biomedical device manufacturing. Front. Chem. 2017, 5, 63. [Google Scholar] [CrossRef] [PubMed]
- Thambiliyagodage, C.; Jayanetti, M.; Mendis, A.; Ekanayake, G.; Liyanaarachchi, H.; Vigneswaran, S. Recent Advances in Chitosan-Based Applications—A Review. Materials 2023, 16, 2073. [Google Scholar] [CrossRef] [PubMed]
- Qiu, Y.L.; Li, Y.; Zhang, G.L.; Hao, H.; Hou, H.M.; Bi, J. Quaternary-ammonium chitosan, a promising packaging material in the food industry. Carbohydr. Polym. 2024, 323, 121384. [Google Scholar] [CrossRef]
- Zou, Y.; Liu, X.; Chen, Q.; Oku, H.; Ma, G.; Wu, J. Acid-Responsive Immune-Enhancing Chitosan Formulation Capable of Transforming from Particle Stabilization to Polymer Chain Stabilization. ACS Appl. Mater. Interfaces 2023, 15, 11403–11415. [Google Scholar] [CrossRef] [PubMed]
- Yilmaz Atay, H. Antibacterial activity of chitosan-based systems. In Functional Chitosan; Springer: Singapore, 2020; pp. 457–489. [Google Scholar] [CrossRef]
- Hao, X.; Jiang, B.; Wu, J.; Xiang, D.; Xiong, Z.; Li, C.; Li, Z.; He, S.; Tu, C.; Li, Z. Nanomaterials for bone metastasis. J. Control. Release 2024, 373, 640–651. [Google Scholar] [CrossRef]
- Nie, Y.; Li, D.; Peng, Y.; Wang, S.; Hu, S.; Liu, M.; Ding, J.; Zhou, W. Metal organic framework coated MnO2 nanosheets delivering doxorubicin and self-activated DNAzyme for chemo-gene combinatorial treatment of cancer. Int. J. Pharm. 2020, 585, 119513. [Google Scholar] [CrossRef]
- Wang, K.; Yin, J.; Chen, J.; Ma, J.; Si, H.; Xia, D. Inhibition of inflammation by berberine: Molecular mechanism and network pharmacology analysis. Phytomedicine 2024, 128, 155258. [Google Scholar] [CrossRef]
- Meissner, J.; Prause, A.; Bharti, B.; Findenegg, G.H. Characterization of protein adsorption onto silica nanoparticles: Influence of pH and ionic strength. Colloid Polym. Sci. 2015, 293, 3381–3391. [Google Scholar] [CrossRef]
- Fernandez-Medina, T.; Vaquette, C.; Gomez-Cerezo, M.N.; Ivanovski, S. Characterization of the Protein Corona of Three Chairside Hemoderivatives on Melt Electrowritten Polycaprolactone Scaffolds. Int. J. Mol. Sci. 2023, 24, 6162. [Google Scholar] [CrossRef] [PubMed]
- Rodrigues, B.; Morais, T.P.; Zaini, P.A.; Campos, C.S.; Almeida-Souza, H.O.; Dandekar, A.M.; Nascimento, R.; Goulart, L.R. Antimicrobial activity of Epsilon-Polylysine against phytopathogenic bacteria. Sci. Rep. 2020, 10, 11324. [Google Scholar] [CrossRef] [PubMed]
- Li, S.; Mao, Y.; Zhang, L.; Wang, M.; Meng, J.; Liu, X.; Bai, Y.; Guo, Y. Recent advances in microbial ε-polylysine fermentation and its diverse applications. Biotechnol. Biofuels Bioprod. 2022, 15, 65. [Google Scholar] [CrossRef] [PubMed]
- Tan, Z.; Shi, Y.; Xing, B.; Hou, Y.; Cui, J.; Jia, S. The antimicrobial effects and mechanism of ε-poly-lysine against Staphylococcus aureus. Bioresour. Bioprocess. 2019, 6, 11. [Google Scholar] [CrossRef]
- Alkekhia, D.; Shukla, A. Influence of polylysine molecular weight on antibacterial efficacy in polymer multilayer films. J. Biomed. Mater. Res. Part A 2019, 107, 1324–1339. [Google Scholar] [CrossRef]
- Chen, S.; Huang, S.; Li, Y.; Zhou, C. Recent Advances in Epsilon-Polylysine and L-Lysine-Based Dendrimer Synthesis, Modification, and Biomedical Applications. Front. Chem. 2021, 9, 659304. [Google Scholar] [CrossRef]
- UNI EN ISO 10993-5:2009; Biological Evaluation of Medical Devices—Part 5: Tests for In Vitro Cytotoxicity. European Committee for Standardization: Brussel, Belgium, 2009.
- Bai, M.; Liu, T.; Liu, B.; Li, Y.; Yu, H.; Zhao, Y.; Yang, C.; Song, L.; Liu, W. Preparation and properties of polyurethane cold galvanizing coatings with phosphoric acid modified zinc powder. Surf. Coat. Technol. 2024, 489, 131128. [Google Scholar] [CrossRef]
- Sun, L.; Jiang, Z.; Yuan, B.; Zhi, S.; Zhang, Y.; Li, J.; Wu, A. Ultralight and superhydrophobic perfluorooctyltrimethoxysilane modified biomass carbonaceous aerogel for oil-spill remediation. Chem. Eng. Res. Des. 2021, 174, 71–78. [Google Scholar] [CrossRef]
- Geng, Z.; Chen, C.; Song, M.; Luo, J.; Chen, J.; Li, R.; Zhou, K. High strength Al0.7CoCrFeNi2.4 hypereutectic high entropy alloy fabricated by laser powder bed fusion via triple-nanoprecipitation. J. Mater. Sci. Technol. 2024, 187, 141–155. [Google Scholar] [CrossRef]
- Li, S.; Chen, N.; Li, Y.; Li, X.; Zhan, Q.; Ban, J.; Zhao, J.; Hou, X.; Yuan, X. Metal-crosslinked ε-polylysine tissue adhesives with high adhesive performance: Inspiration from mussel adhesive environment. Int. J. Biol. Macromol. 2020, 153, 1251–1261. [Google Scholar] [CrossRef]
- Yang, Q.; Xie, Z.; Hu, J.; Liu, Y. Hyaluronic acid nanofiber mats loaded with antimicrobial peptide towards wound dressing applications. Mater. Sci. Eng. C 2021, 128, 112319. [Google Scholar] [CrossRef]
- Palecek, A.M.; Garner, A.M.; Klittich, M.R.; Stark, A.Y.; Scherger, J.D.; Bernard, C.; Niewiarowski, P.H.; Dhinojwala, A. An investigation of gecko attachment on wet and rough substrates leads to the application of surface roughness power spectral density analysis. Sci. Rep. 2022, 12, 11556. [Google Scholar] [CrossRef] [PubMed]
- Losertová, M.; Štefek, O.; Galajda, M.; Konečná, K.; Martynková, G.S.; Barabaszová, K.Č. Microstructure and Electrochemical Behavior of TiO2 Nanotubes Coated on Titanium-Based Substrate Before and After Thermal Treatment. J. Nanosci. Nanotechnol. 2018, 19, 2989–2996. [Google Scholar] [CrossRef] [PubMed]
- Alinejad-Mofrad, E.; Malaekeh-Nikouei, B.; Gholami, L.; Mousavi, S.H.; Sadeghnia, H.R.; Mohajeri, M.; Darroudi, M.; Oskuee, R.K. Evaluation and comparison of cytotoxicity, genotoxicity, and apoptotic effects of poly-l-lysine/plasmid DNA micro- and nanoparticles. Hum. Exp. Toxicol. 2019, 38, 983–991. [Google Scholar] [CrossRef] [PubMed]
- Hall, A.; Wu, L.P.; Parhamifar, L.; Moghimi, S.M. Moghimi, Differential Modulation of Cellular Bioenergetics by Poly(L-lysine)s of Different Molecular Weights. Biomacromolecules 2015, 16, 2119–2126. [Google Scholar] [CrossRef]
- Abbasi, M.S.; Bahrami, A.; Hosseini-Abari, A.S.; Saber, F.Y. Synthesis and characterization of composite coating of iron oxide and bioactive glass, coated by electrophoretic co-deposition method for biomedical applications. J. Adv. Mater. Eng. 2023, 42, 1–13. [Google Scholar]

Disclaimer/Publisher’s Note: The statements, opinions and data contained in all publications are solely those of the individual author(s) and contributor(s) and not of MDPI and/or the editor(s). MDPI and/or the editor(s) disclaim responsibility for any injury to people or property resulting from any ideas, methods, instructions or products referred to in the content. |
© 2024 by the authors. Licensee MDPI, Basel, Switzerland. This article is an open access article distributed under the terms and conditions of the Creative Commons Attribution (CC BY) license (https://creativecommons.org/licenses/by/4.0/).
Share and Cite
Jalali Dehkordi, M.; Bahrami, A.; Abbasi, M.S.; Mokhtari, M.A.; Heidari Laybidi, F.; Roosefid, A.; Hosseini-Abari, A.; Yazdan Mehr, M. Surface Modification of Anodized Titanium Surfaces with Chitosan/ε-Polylysine Coating, Aiming for Improved Bioactivity, Biocompatibility, and Anti-Bacterial Properties for Orthopedic Applications. Coatings 2024, 14, 1522. https://doi.org/10.3390/coatings14121522
Jalali Dehkordi M, Bahrami A, Abbasi MS, Mokhtari MA, Heidari Laybidi F, Roosefid A, Hosseini-Abari A, Yazdan Mehr M. Surface Modification of Anodized Titanium Surfaces with Chitosan/ε-Polylysine Coating, Aiming for Improved Bioactivity, Biocompatibility, and Anti-Bacterial Properties for Orthopedic Applications. Coatings. 2024; 14(12):1522. https://doi.org/10.3390/coatings14121522
Chicago/Turabian StyleJalali Dehkordi, Mahshid, Abbas Bahrami, Mohammad Saeid Abbasi, Mohammad Amin Mokhtari, Farnaz Heidari Laybidi, Ali Roosefid, Afrouzossadat Hosseini-Abari, and Maryam Yazdan Mehr. 2024. "Surface Modification of Anodized Titanium Surfaces with Chitosan/ε-Polylysine Coating, Aiming for Improved Bioactivity, Biocompatibility, and Anti-Bacterial Properties for Orthopedic Applications" Coatings 14, no. 12: 1522. https://doi.org/10.3390/coatings14121522
APA StyleJalali Dehkordi, M., Bahrami, A., Abbasi, M. S., Mokhtari, M. A., Heidari Laybidi, F., Roosefid, A., Hosseini-Abari, A., & Yazdan Mehr, M. (2024). Surface Modification of Anodized Titanium Surfaces with Chitosan/ε-Polylysine Coating, Aiming for Improved Bioactivity, Biocompatibility, and Anti-Bacterial Properties for Orthopedic Applications. Coatings, 14(12), 1522. https://doi.org/10.3390/coatings14121522

